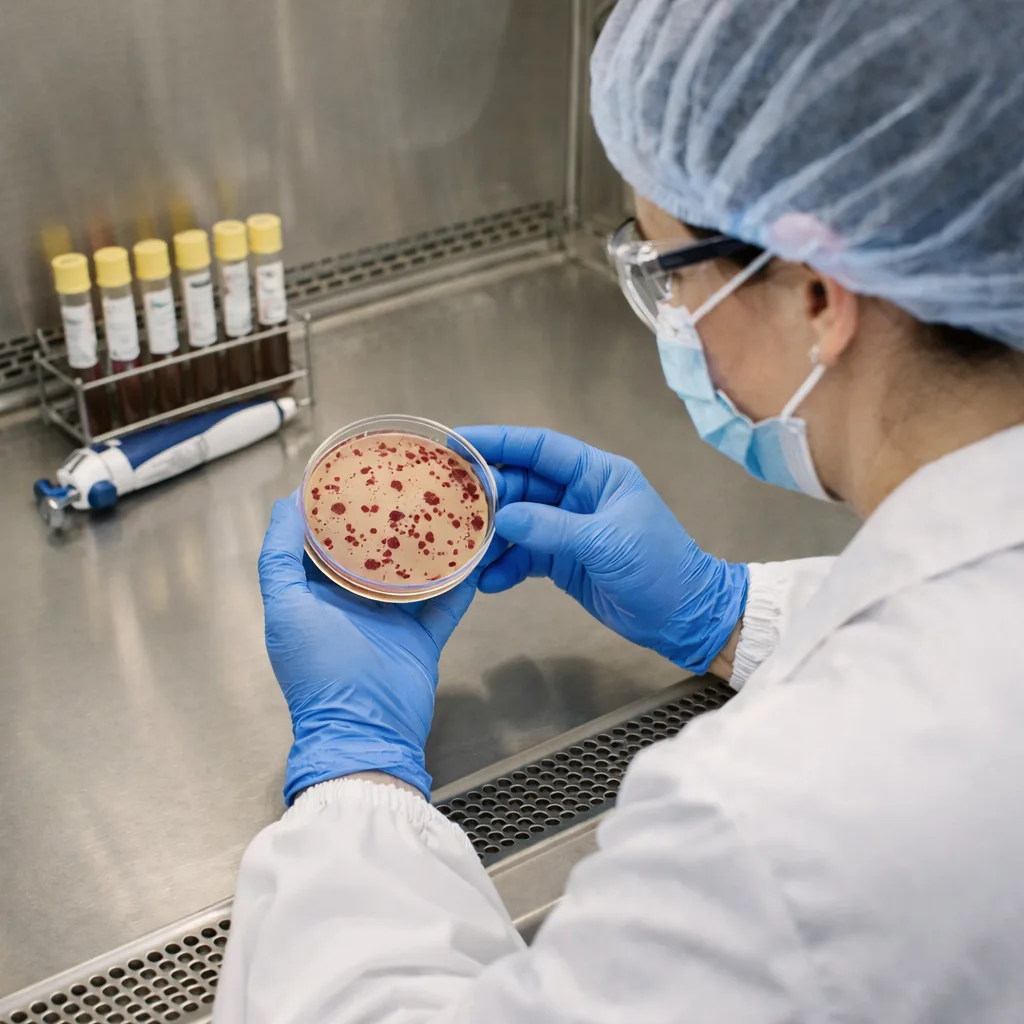
Pathogen Screening

BioTrace operates as a specialized microbiological testing laboratory delivering accurate, defensible data aligned with FDA standards and globally accepted analytical methods for food, nutraceutical, herbal, cosmetic, and agricultural products. Our programs help manufacturers verify hygiene, detect contamination risks, and meet regulatory expectations with confidence.
From routine enumeration to pathogen detection, our programs cover every critical microbial risk across your supply chain, supporting FDA compliance and globally recognized microbiological testing frameworks.

TPC estimates the total viable aerobic bacteria in a product — the gold-standard indicator of manufacturing cleanliness across food, dairy, beverages, pharmaceuticals, and cosmetics. Routine TPC evaluation helps identify process deviations before they become costly batch failures.
Reveals microbial exposure from unsafe water, low-grade inputs, or inadequate sanitation practices.
Elevated counts signal increased spoilage probability and potential safety risks.
Controlled loads strengthen confidence in product stability and expected shelf life.
Trending results across batches helps optimize processing and identify hygiene gaps early.

Identifies fungal organisms responsible for spoilage in fruits, vegetables, spices, and plant-derived materials. Critical for product stability, preservation strategies, and long-term storage reliability, while detecting contaminated inputs before they impact batch integrity and compliance with FDA and global safety standards.
Prevents mycotoxin risks and protects consumers from long-term health implications.
Visible discoloration, dark spots, or unusual odors suggest active fungal growth.
Validates product acceptability and understanding of humidity and packaging risk factors.
Identifies contamination root causes and supports batch-wise shelf life validation.
Detects harmful organisms that can lead to serious foodborne illness and regulatory action. Fundamental for preventive control programs, export readiness, and brand protection. Our testing panel covers critical food safety pathogens required for compliance with FDA requirements, FSMA preventive controls, and global food safety frameworks.
Early detection reduces recall exposure and safeguards public health.
Surface slime, abnormal moisture, or package integrity issues may signal microbial activity.
Validated pathogen testing ensures products meet safety expectations across all buyer categories.
Reports enable manufacturers to strengthen preventive systems and implement corrective measures.

A key hygiene indicator reflecting contamination from water sources, equipment, or handling environments. Especially critical for fresh produce, minimally processed foods, and ready-to-use materials where sanitation directly impacts product safety and shelf stability, aligned with FDA guidelines and global food safety standards.
Determines sanitation effectiveness and enables early intervention before quality deteriorates.
Sticky textures, slime formation, or improper temperature control indicate elevated contamination risk.
Confirms whether hygiene controls are functioning as intended within the production environment.
Supports safer water usage, improved cleaning protocols, and stronger contamination control strategies.

BioTrace conducts testing in accordance with recognized FDA regulations and globally accepted microbiological standards relevant to manufacturing, retail, and international supply chains. Strict microbial limits, validated methodologies, and structured documentation help organizations demonstrate due diligence and product integrity.
Regulatory compliance is essential for market access, certification, and brand protection.
Structured COAs integrate smoothly into audit and inspection environments worldwide.
Documented compliance improves buyer trust and significantly reduces approval delays.
Find answers to common questions about our microbiological testing services
Accurate composition, purity verification, and FDA-aligned documentation—delivered with the precision your quality and regulatory teams expect.